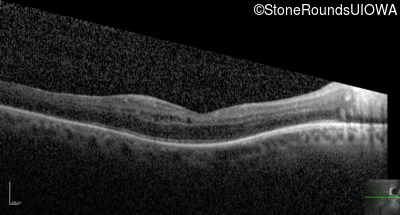
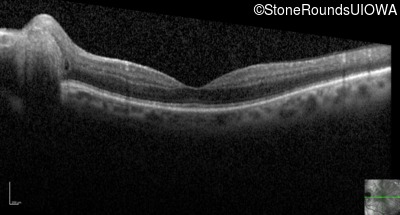
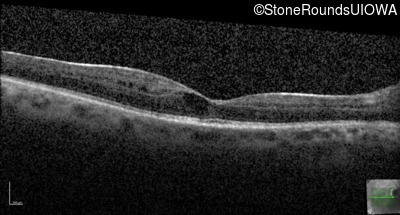
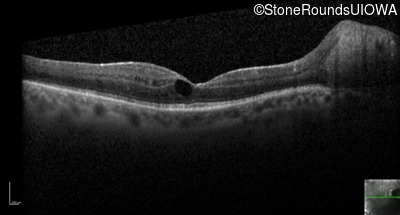
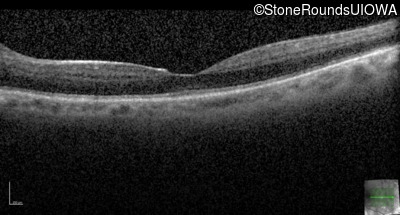
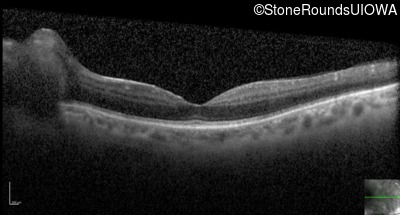

Case
SR28
Student Mode
Enhanced S-Cone Syndrome (IA2fiv)
Male
Male
Hidden
SR28
Student Mode
Enhanced S-Cone Syndrome (IA2fiv)
Male
Male
Visit at age: 23 years
Fundus Photography - Right - 20/80
Fundus Photography - Left - 20/20 -2
Goldmann Visual Field - Right - 20/80
Goldmann Visual Field - Left - 20/20 -2
Fluorescein Angiography - Right - 20/80
Fluorescein Angiography - Left - 20/20 -2
Visit at age: 37 years
Fundus Photography - Right - 20/80 -2
Fundus Photography - Left - 20/25 -1
Fundus Montage - Right - 20/80 -2
Fundus Montage - Left - 20/25 -1
Goldmann Visual Field - Right - 20/80 -2
Goldmann Visual Field - Left - 20/25 -1
Optical Coherence Tomography - Right - 20/80 -2
Optical Coherence Tomography - Left - 20/25 -1
Infrared Fundus Photograph - Right - 20/80 -2
Infrared Fundus Photograph - Left - 20/25 -1
Visit at age: 38 years
Fundus Photography - Right - 20/80
Fundus Photography - Left - 20/30 +2
Optical Coherence Tomography - Right - 20/80
Optical Coherence Tomography - Left - 20/30 +2
Infrared Fundus Photograph - Right - 20/80
Infrared Fundus Photograph - Left - 20/30 +2
Case Level Images

Diagnosis & molecular findings
| Disease | Gene | Allele 1 variant(s) | Allele 2 variant(s) | Inheritance mode |
|---|---|---|---|---|
| Enhanced S-Cone Syndrome | NR2E3 | Arg311Gln CGG>CAG | Arg73Ser AGG>AGC | AR |
Disease:
Gene:
Allele 1:
Arg311Gln CGG>CAG
Allele 2:
Arg73Ser AGG>AGC
Inheritance:
AR